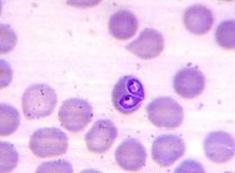
Ilustracja do pytania

Pytanie 1
Zwierzęta podczas uboju gospodarczego mogą być zabijane jedynie po wcześniejszym pozbawieniu ich świadomości przez
Wynik: 15/40 punktów (37,5%)
Wymagane minimum: 20 punktów (50%)
Zwierzęta podczas uboju gospodarczego mogą być zabijane jedynie po wcześniejszym pozbawieniu ich świadomości przez
Co oznacza sedacja?
Tętno u bydła można zmierzyć na tętnicy
W jakim zakresie powinna wynosić prawidłowa liczba oddechów zdrowego konia w stanie spoczynku?
Zadania dotyczące walki z chorobami zakaźnymi u zwierząt są realizowane z urzędu przez
Podczas wystąpienia brucelozy u bydła można zauważyć wyciek z
Kto dokonuje powołania Głównego Lekarza Weterynarii?
Aby chronić prosięta przed niedoborem żelaza, należy w ciągu trzech dni po urodzeniu podać odpowiednie preparaty
Opisane objawy towarzyszą
| Schorzenie występuje u zwierząt młodych, rozwija się bardzo powoli, czasami nawet w przeciągu kilku miesięcy. Jego początkiem jest zazwyczaj powiększenie stawów skokowych i nadgarstkowych, a także różańcowate zgrubienia na końcach żeber. Oprócz tego może wystąpić bolesność i kulawizna kończyn, wklęśnięcie kręgosłupa, łukowate wygięcie kończyn, zmiany na zębach (uszkodzone szkliwo, opóźniona wymiana zębów mlecznych na stałe). Czasami występują bardziej ogólne objawy, jak niechęć do ruchu, brak apetytu i osowiałość, osłabienie odporności organizmu. |
U zdrowego psa do analizy dostępne są węzły chłonne
W kurniku z sztucznym oświetleniem kura nioska powinna być pozbawiona światła przez
Jak długo po przeprowadzeniu zabiegu sterylizacji suki usuwa się szwy zewnętrzne ze skóry?
Przeprowadzenie badania w kierunku obecności pałeczek Salmonella jest niezbędne przed skierowaniem do uboju
Aby ocenić, czy żwacz bydła jest wypełniony gazami, należy opukać jego
Na wyniku morfologii krwi psa znajduje się informacja: PLT 850 (200-580 tys./μl). Co oznacza ten rezultat?
Termin odnoszący się do sytuacji, w której wirusy są obecne w krwi i mają zdolność do namnażania się, to
U zwierzęcia po urazie zaobserwowano rozszerzone, niereagujące na światło źrenice oraz brak odruchu rogówkowego. Jakie jest rokowanie w tej sytuacji?
Przedstawiony na rysunku obraz świadczy o
Jaką chorobę wywołują pierwotniaki?
Na podstawie fragmentu ustawy określ, ile lat pozbawienia wolności grozi osobie znęcającej się nad zwierzęciem ze szczególnym okrucieństwem.
| Art. 35. 1. Kto zabija, uśmierca zwierzę albo dokonuje uboju zwierzęcia z naruszeniem przepisów art. 6 ust. 1, art. 33 lub art. 34 ust. 1–4 podlega grzywnie, karze ograniczenia wolności albo pozbawienia wolności do lat 2. 1a. Tej samej karze podlega ten, kto znęca się nad zwierzęciem. 2. Jeżeli sprawca czynu określonego w ust. 1 lub 1a działa ze szczególnym okrucieństwem podlega karze pozbawienia wolności do lat 3. 3. W razie skazania za przestępstwo określone w ust. 1, 1a lub 2 sąd orzeka przepadek zwierzęcia, jeżeli sprawca jest jego właścicielem. 3a. W razie skazania za przestępstwo określone w ust. 1 lub 1a sąd może orzec, a w razie skazania za przestępstwo określone w ust. 2 sąd orzeka tytułem środka karnego zakaz posiadania zwierząt od roku do lat 10; zakaz orzeka się w latach. 4.W razie skazania za przestępstwo określone w ust. 1, 1a lub 2, sąd może orzec wobec sprawcy zakaz wykonywania określonego zawodu, prowadzenia określonej działalności lub wykonywania czynności wymagających zezwolenia, które są związane z wykorzystywaniem zwierząt lub oddziaływaniem na nie, a także może orzec przepadek narzędzi lub przedmiotów służących do popełnienia przestępstwa oraz przedmiotów pochodzących z przestępstwa. 5. W razie skazania za przestępstwo określone w ust. 1, 1a lub 2, sąd może orzec nawiązkę w wysokości od 500 zł do 100 000 zł na cel związany z ochroną zwierząt, wskazany przez sąd. |
Do grupy 3 produktów ubocznych pochodzenia zwierzęcego zaliczamy
Mięso jakich zwierząt podlega obowiązkowemu badaniu na obecność larw włośni?
Aby unieruchomić zwierzę, zabrania się używania prądu elektrycznego, który nie powoduje ogłuszenia ani nie prowadzi do śmierci w warunkach kontrolowanych, szczególnie mowa tu o prądzie elektrycznym, który nie przepływa przez
W tabeli podano prawidłowe wskaźniki hematologiczne dla różnych gatunków zwierząt. Które ze zwierząt ma leukocytozę?
| Wskaźnik | Leukocyty (LEU) | ||
|---|---|---|---|
| Jednostka | 10³/l | tys./mm³ | |
| Gatunek | Konie | 6,0–12,0 | 6,0–12,0 |
| Bydło | 4,0–10,0 | 4,0–10,0 | |
| Owce | 4,0–12,0 | 4,0–12,0 | |
| Kozy | 5,0–13,0 | 5,0–13,0 | |
| Świnie | 10,0–22,0 | 10,0–22,0 | |
| Psy | 6,0–17,0 | 6,0–17,0 | |
| Koty | 5,0–20,0 | 5,0–20,0 | |
Dokument "Informacje dotyczące łańcucha pokarmowego zwierząt przeznaczonych do uboju" wypełnia
Wartość saturacji krwi wynosząca 95%, wyświetlana na kardiomonitorze w trakcie operacji, odnosi się do poziomu
Na podstawie informacji dotyczącej sposobu przeprowadzenia odkażania w przypadku podejrzenia enzootycznej białaczki bydła, określ ile litrów środka biobójczego potrzeba do profilaktycznego odkażenia 30 metrów kwadratowych powierzchni.
(...) III. Odkażanie 1.Odkażanie polegające na niszczeniu czynników chorobotwórczych obecnych w środowisku jest przeprowadzane przy użyciu: 1) środków fizycznych; 2) produktów biobójczych dopuszczonych do obrotu na podstawie przepisów o produktach biobójczych; 3) środków biologicznych (z udziałem bakterii nitryfikacyjnych) stosowanych do odkażania obornika i gnojowicy. 2.Odkażanie przy użyciu produktów biobójczych polega na zastosowaniu: 1) pół litra roztworu takiego produktu na 1 m2 powierzchni – w przypadku odkażania profilaktycznego; 2) co najmniej jednego litra roztworu środka dezynfekcyjnego na 1 m2 powierzchni |
Narzędzie przedstawione na rysunku to kleszcze

W wyniku śmierci zwierzęcia w krwioobiegu pojawiają się
Jakie jest miejsce predylekcyjne u trzody, w którym rozwija się Trichinella spiralis?
Oblicz, ile preparatu AGRISAN 8090 będzie konieczne do posypania ściółki w pomieszczeniu inwentarskim o wymiarach 2 m x 4 m, mając na uwadze, że zalecana dawka preparatu wynosi 50 g na 1 m2?
Babeszjoza jest przenoszona przez jakie organizmy?
Podczas przeprowadzania badania przedubojowego zwierzęcia nie da się wykluczyć
Ile środka należy podać cielakowi ważącemu 135 kg, który ma zdiagnozowane wzdęcie żołądka, jeśli lekarz zalecił stosowanie preparatu o nazwie Buscopan compositum VET, którego dawkowanie wynosi 0,8 ml na 10 kg masy ciała i.m?
W trakcie identyfikacji włośni poprzez wytrawianie dochodzi do uwolnienia larw
Kleszcze przedstawione na zdjęciu służą do wykonania zabiegu

Gdzie odbywa się odpoczynek bydła przed ubiciem?
Jak długo można trzymać psa na smyczy?
Zabicie wszystkich zwierząt podatnych w siedzibie stada będzie miało miejsce w przypadku wykrycia
Do sporządzenia roztworu NaCl o stężeniu 26,5% w celu analizy kału, jakie składniki powinny zostać zastosowane?